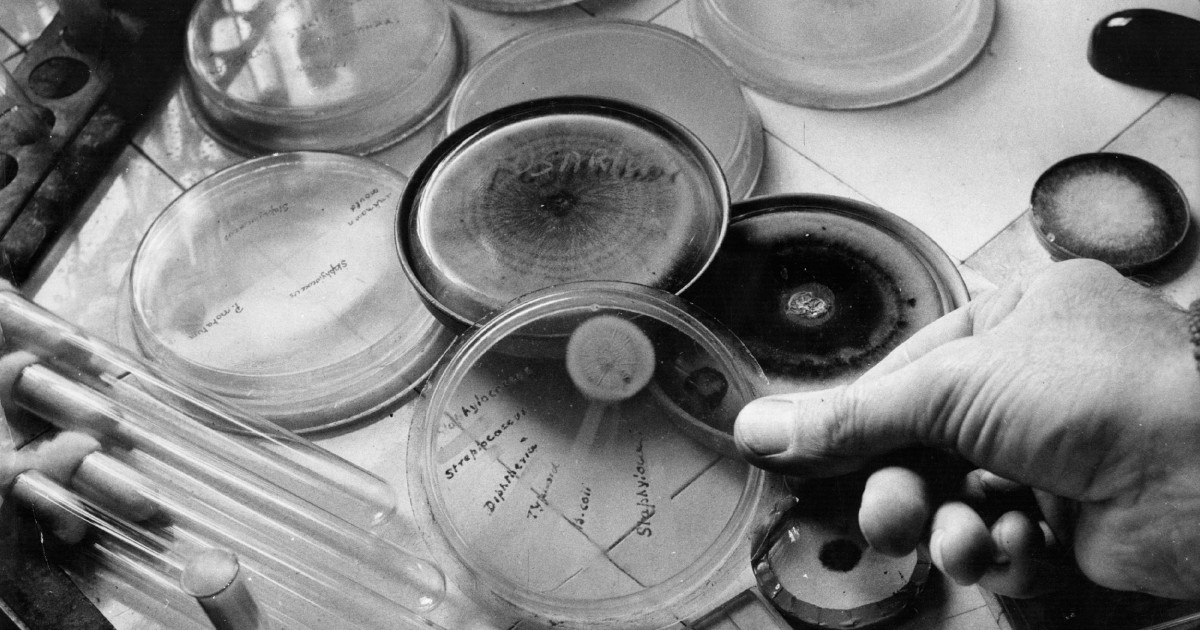

Is penicillin vk an antibiotic. Penicillin VK: A Comprehensive Guide to This Powerful Antibiotic
What is penicillin VK. How does penicillin VK work. What infections does penicillin VK treat. What are the side effects of penicillin VK. How should penicillin VK be taken. Who should not take penicillin VK. What precautions should be taken with penicillin VK.
Understanding Penicillin VK: An Essential Antibiotic
Penicillin VK, also known as penicillin V potassium, is a widely prescribed antibiotic medication. It belongs to the penicillin family of antibiotics, which have been instrumental in treating bacterial infections since their discovery. This article delves into the various aspects of penicillin VK, providing valuable information for patients and healthcare professionals alike.
What is Penicillin VK?
Penicillin VK is an oral antibiotic used to treat a variety of bacterial infections. It comes in tablet form and is available by prescription only. The medication works by interfering with the cell wall formation of susceptible bacteria, ultimately leading to their destruction.

How does Penicillin VK differ from other antibiotics?
Penicillin VK is a narrow-spectrum antibiotic, meaning it is effective against specific types of bacteria. This targeted approach helps reduce the risk of antibiotic resistance and minimizes the impact on beneficial bacteria in the body. Unlike broad-spectrum antibiotics, which affect a wide range of bacteria, penicillin VK is particularly effective against certain gram-positive bacteria.
The Mechanism of Action: How Penicillin VK Fights Infections
Understanding how penicillin VK works is crucial for appreciating its effectiveness in treating bacterial infections. The medication operates through a specific mechanism that targets the structural integrity of bacterial cells.
Inhibition of Cell Wall Synthesis
Penicillin VK primarily works by inhibiting the synthesis of bacterial cell walls. It interferes with the cross-linking of peptidoglycan, a crucial component of bacterial cell walls. This interference weakens the cell wall, making it susceptible to osmotic pressure and ultimately leading to cell lysis or death.

Bactericidal Action
Unlike some antibiotics that merely inhibit bacterial growth, penicillin VK is bactericidal. This means it actively kills bacteria rather than just preventing their reproduction. This bactericidal action makes penicillin VK particularly effective in treating acute infections.
Common Uses of Penicillin VK: Treating Various Infections
Penicillin VK is prescribed for a range of bacterial infections. Its effectiveness against specific types of bacteria makes it a go-to choice for certain conditions.
Respiratory Tract Infections
Penicillin VK is commonly used to treat upper respiratory tract infections, including:
- Streptococcal pharyngitis (strep throat)
- Tonsillitis
- Sinusitis
Skin and Soft Tissue Infections
The antibiotic is also effective against certain skin and soft tissue infections, such as:
- Cellulitis
- Erysipelas
- Impetigo
Dental Infections
Penicillin VK is often prescribed for dental infections, including:
- Periodontal abscesses
- Gingivitis
Dosage and Administration: Proper Use of Penicillin VK
Correct dosage and administration of penicillin VK are crucial for its effectiveness and safety. Healthcare providers determine the appropriate dosage based on several factors.

Standard Dosage for Adults
For adults and children over 12 years old, the typical dosage ranges from 1 to 4 grams daily, divided into 3 to 4 doses. The exact dosage depends on the severity and type of infection being treated.
Pediatric Dosing
For children under 12, the dosage is based on body weight. The recommended daily dose ranges from 25 mg to 100 mg per kg of body weight, divided into 3 or 4 equal doses.
Administration Guidelines
To ensure optimal absorption and effectiveness, penicillin VK should be taken:
- On an empty stomach, either 1 hour before or 2 hours after meals
- With a full glass of water
- At evenly spaced intervals throughout the day
Side Effects and Precautions: What to Watch For
While penicillin VK is generally well-tolerated, it can cause side effects in some individuals. Being aware of these potential side effects and taking necessary precautions is essential for safe use.
Common Side Effects
Some of the more common side effects of penicillin VK include:

- Nausea and vomiting
- Diarrhea
- Stomach pain
- Skin rash
- Black hairy tongue (a harmless condition that resolves after discontinuing the medication)
Serious Side Effects
While rare, some serious side effects may occur and require immediate medical attention:
- Severe allergic reactions (anaphylaxis)
- Severe skin reactions
- Clostridium difficile-associated diarrhea
Precautions and Contraindications
Penicillin VK should not be used in individuals with:
- Known allergy to penicillin or other beta-lactam antibiotics
- Certain types of severe infections
- History of penicillin-associated cholestatic hepatitis
Drug Interactions: Potential Conflicts with Other Medications
Understanding potential drug interactions is crucial for safe and effective use of penicillin VK. Certain medications can affect its efficacy or increase the risk of side effects.
Common Drug Interactions
Penicillin VK may interact with:
- Oral contraceptives (potentially reducing their effectiveness)
- Probenecid (which can increase penicillin levels in the blood)
- Methotrexate (penicillin may increase its toxicity)
- Certain antibiotics (which may reduce penicillin’s effectiveness)
Managing Drug Interactions
To minimize the risk of drug interactions:

- Inform your healthcare provider about all medications you are taking
- Do not start or stop any medications without consulting your doctor
- Follow dosing instructions carefully
Antibiotic Resistance: The Importance of Proper Use
Antibiotic resistance is a growing concern in healthcare. Proper use of penicillin VK and other antibiotics is crucial in combating this issue.
Causes of Antibiotic Resistance
Factors contributing to antibiotic resistance include:
- Overuse of antibiotics
- Improper use (e.g., not completing the full course of treatment)
- Use of antibiotics for viral infections
Preventing Antibiotic Resistance
To help prevent antibiotic resistance:
- Only use antibiotics when prescribed by a healthcare professional
- Complete the full course of treatment, even if symptoms improve
- Do not share antibiotics with others
- Practice good hygiene to prevent the spread of infections
Penicillin VK in Pregnancy and Breastfeeding: Safety Considerations
The use of penicillin VK during pregnancy and breastfeeding requires careful consideration. While generally considered safe, it’s important to weigh the potential risks and benefits.

Penicillin VK in Pregnancy
Penicillin VK is classified as FDA pregnancy category B, meaning it is generally considered safe during pregnancy. However, it should only be used when clearly needed and under the supervision of a healthcare provider.
Penicillin VK and Breastfeeding
Penicillin VK does pass into breast milk in small amounts. While it’s generally considered safe for breastfeeding mothers, potential risks to the infant should be discussed with a healthcare provider.
Precautions for Pregnant and Breastfeeding Women
Women who are pregnant or breastfeeding should:
- Inform their healthcare provider of their pregnancy or breastfeeding status
- Discuss the potential risks and benefits of penicillin VK treatment
- Follow dosing instructions carefully
- Monitor for any adverse effects in themselves or their infants
Alternatives to Penicillin VK: Options for Allergic Patients
For individuals allergic to penicillin or in cases where penicillin VK is not effective, alternative antibiotics may be prescribed.
Common Alternatives
Alternatives to penicillin VK may include:
- Macrolides (e.g., erythromycin, azithromycin)
- Cephalosporins (for patients without severe penicillin allergy)
- Fluoroquinolones
- Tetracyclines
Choosing an Alternative
The choice of alternative antibiotic depends on several factors:
- The type and severity of the infection
- The patient’s allergy history
- Local patterns of antibiotic resistance
- Potential drug interactions
Historical Significance: The Discovery and Impact of Penicillin
The discovery of penicillin marked a turning point in medical history, revolutionizing the treatment of bacterial infections and saving countless lives.
Discovery of Penicillin
Penicillin was discovered by Alexander Fleming in 1928 when he noticed that mold growing on a Petri dish inhibited the growth of bacteria. This accidental discovery led to the development of the first antibiotic.
Impact on Medicine
The introduction of penicillin in the 1940s dramatically reduced mortality rates from bacterial infections. It played a crucial role in:
- Treating infections during World War II
- Reducing deaths from pneumonia, scarlet fever, and other bacterial infections
- Enabling more complex surgical procedures by preventing post-operative infections
Ongoing Importance
Despite the development of many new antibiotics, penicillin and its derivatives remain important in modern medicine due to their:
- Effectiveness against many common bacterial infections
- Relatively low cost
- Well-understood safety profile
Future of Antibiotics: Research and Development
As antibiotic resistance continues to be a global health concern, ongoing research and development in the field of antibiotics is crucial.

Current Research Areas
Current antibiotic research focuses on:
- Developing new classes of antibiotics
- Improving existing antibiotics to overcome resistance
- Exploring alternative approaches to treating bacterial infections
Promising Developments
Some promising areas in antibiotic research include:
- CRISPR-based antibiotics
- Bacteriophage therapy
- Antimicrobial peptides
- Combination therapies to combat resistance
Challenges in Antibiotic Development
Developing new antibiotics faces several challenges:
- High costs of research and development
- Regulatory hurdles
- Limited financial incentives for pharmaceutical companies
- The rapid emergence of resistance to new antibiotics
In conclusion, penicillin VK remains a valuable tool in the fight against bacterial infections. Its effectiveness, relatively low cost, and well-established safety profile make it a cornerstone of antibiotic therapy. However, the growing threat of antibiotic resistance underscores the importance of proper use and ongoing research into new antimicrobial strategies. As we continue to rely on penicillin VK and other antibiotics, it’s crucial to use them responsibly and to support efforts to develop new weapons against bacterial infections.

Pen-VK – Uses, Side Effects, Interactions
How does this medication work? What will it do for me?
Penicillin belongs to the family of medications known as antibiotics. Penicillin is used to treat infections caused by certain bacteria. It is most commonly used to treat certain throat, respiratory tract, and skin infections. It may be used to prevent certain infections in people whose bodies areunable to fight infections. It works by killing or preventing the growth of bacteria that cause the infection.
This medication may be available under multiple brand names and/or in several different forms. Any specific brand name of this medication may not be available in all of the forms or approved for all of the conditions discussed here. As well, some forms of this medication may not be used for all of the conditions discussed here.
Your doctor may have suggested this medication for conditions other than those listed in these drug information articles.
If you have not discussed this with your doctor or are not sure why you are taking this medication, speak to your doctor. Do not stop taking this medication without consulting your doctor.
Do not give this medication to anyone else, even if they have the same symptoms as you do. It can be harmful for people to take this medication if their doctor has not prescribed it.
What form(s) does this medication come in?
Each orange, film-coated, round, biconvex tablet, scored and engraved “300” on one side and plain on the other side, contains 300 mg of penicillin V potassium (equivalent to 480,000 IU). Nonmedicinal ingredients: colloidal silicon dioxide, croscarmellose sodium, FD&C Yellow No. 10 Aluminum Lake, hydroxypropyl cellulose, magnesium stearate, methylcellulose, polyethylene glycol, purified water, sunset yellow aluminum lake, and titanium dioxide.
How should I use this medication?
The recommended dose of penicillin for adults and children varies according to the infection being treated.
The recommended dose for adults and children over 12 years old ranges from 1 to 4 grams daily, divided into 3 to 4 doses.
The dose for children under 12 years old is based on body weight. The recommended daily dose ranges from 25 mg to 100 mg per kg of body weight and is divided into 3 or 4 equal doses.
Many things can affect the dose of medication that a person needs, such as body weight, other medical conditions, and other medications. If your doctor has recommended a dose different from the ones listed here, do not change the way that you are taking the medication without consulting your doctor.
When taken by mouth, penicillin should be taken on an empty stomach, either 1 hour before or 2 hours after meals.
Finish all this medication, even if you have started to feel better. This will reduce the chance of the infection returning.
It is important to take this medication exactly as prescribed by your doctor. If you miss a dose, take it as soon as possible and continue with your regular schedule.
If it is almost time for your next dose, skip the missed dose and continue with your regular dosing schedule. Do not take a double dose to make up for a missed one. If you are not sure what to do after missing a dose, contact your doctor or pharmacist for advice.
Store this medication at room temperature and keep it out of the reach of children.
Do not dispose of medications in wastewater (e.g. down the sink or in the toilet) or in household garbage. Ask your pharmacist how to dispose of medications that are no longer needed or have expired.
Who should NOT take this medication?
Do not take this medication if you:
- are allergic to penicillin or any ingredients of the medication
- have certain types of severe infections
What side effects are possible with this medication?
Many medications can cause side effects. A side effect is an unwanted response to a medication when it is taken in normal doses.
Side effects can be mild or severe, temporary or permanent.
The side effects listed below are not experienced by everyone who takes this medication. If you are concerned about side effects, discuss the risks and benefits of this medication with your doctor.
The following side effects have been reported by at least 1% of people taking this medication. Many of these side effects can be managed, and some may go away on their own over time.
Contact your doctor if you experience these side effects and they are severe or bothersome. Your pharmacist may be able to advise you on managing side effects.
- black hairy tongue
- bloating
- diarrhea
- heartburn
- nausea
- skin rash
- stomach pains
- vomiting
Although most of the side effects listed below don’t happen very often, they could lead to serious problems if you do not seek medical attention.
Check with your doctor as soon as possible if any of the following side effects occur:
- fever, itchy skin, muscle pain, swollen glands, general feeling of being unwell
- numbness or weakness in the extremities
- signs of anemia (low red blood cells; e.
g., dizziness, pale skin, unusual tiredness or weakness, shortness of breath) - signs of clotting problems (e.g., unusual nosebleeds, bruising, blood in urine, coughing blood, bleeding gums, cuts that don’t stop bleeding)
- signs of liver problems, e.g.:
- dark urine
- diarrhea
- loss of appetite
- nausea
- pale stools
- vomiting
- weight loss
- yellowing of the skin or whites of the eyes
Stop taking the medication and seek immediate medical attention if any of the following occur:
- diarrhea (watery and severe; may also be bloody)
- fever that appears after starting the antibiotic
- seizures
- signs of a serious allergic reaction, e.g.:
- abdominal cramps
- difficulty breathing
- nausea and vomiting
- swelling of the face and throat
- signs of a severe skin reaction, e.g.:
- a rash combined with fever or discomfort
- a rash covering a large area of the body
- a rash that spreads quickly
- blistering
- peeling
Some people may experience side effects other than those listed.
Check with your doctor if you notice any symptom that worries you while you are taking this medication.
Are there any other precautions or warnings for this medication?
Before you begin taking a medication, be sure to inform your doctor of any medical conditions or allergies you may have, any medications you are taking, whether you are pregnant or breast-feeding, and any other significant facts about your health. These factors may affect how you should take this medication.
Allergy: Some people who are allergic to cephalosporin antibiotics also experience allergic reactions to penicillin. Before you take penicillin, inform your doctor about any previous adverse reactions you have had to medications, especially cephalosporins and other penicillins. Contact your doctor at once if you experience signs of an allergic reaction, such as skin rash, itching, difficulty breathing or swelling of the face and throat.
Antibiotic-associated colitis: This medication, like other antibiotics, may cause a potentially dangerous condition called antibiotic-associated, or pseudomembranous, colitis.
Symptoms include severe, watery diarrhea that may be bloody. If you notice these symptoms, stop taking penicillin and contact your doctor as soon as possible.
Bacterial resistance: Misuse of an antibiotic such as penicillin may lead to the growth of resistant bacteria that will not be killed by the antibiotic. If this happens, the antibiotic may not work for you in the future. Although you may begin to feel better when you first start taking penicillin, you need to take all of the medication exactly as prescribed by your doctor to finish ridding your body of the infection and to prevent resistant bacteria from taking hold. Do not take penicillin or other antibiotics to treat a viral infection such as the common cold; antibiotics do not kill viruses, and using them to treat viral infections can lead to the growth of resistant bacteria.
Birth control: Whether penicillin decreases the effectiveness of birth control pills is controversial. Some doctors recommend adding another method of birth control for the rest of the menstrual cycle when penicillin is taken.
Kidney function: Penicillin is removed from the body by the kidneys. People with impaired kidney function are at risk of increased side effects and may need lower doses of penicillin. People with kidney disease or reduced kidney function should discuss with their doctor how this medication may affect their medical condition, how their medical condition may affect the dosing and effectiveness of this medication, and whether any special monitoring is needed.
Overgrowth of organisms: Prolonged treatment with penicillin may allow normal fungus or types of bacteria not killed by the antibiotic to overgrow, causing unwanted infections such as yeast infections.
Pregnancy: Usual doses of penicillin appear to be safe during pregnancy.
Breast-feeding: This medication passes into breast milk. If you are a breast-feeding mother and are taking penicillin, it may affect your baby. Talk to your doctor about whether you should continue breast-feeding.
What other drugs could interact with this medication?
There may be an interaction between penicillin and any of the following:
- BCG
- birth control pills
- chloramphenicol
- cholera vaccine
- erythromycin
- fusidic acid
- methotrexate
- mycophenolate
- teriflunomide
- tetracycline antibiotics (e.g., doxycycline, minocycline, tetracycline)
- tolvaptan
- typhoid vaccine
- warfarin
If you are taking any of these medications, speak with your doctor or pharmacist. Depending on your specific circumstances, your doctor may want you to:
- stop taking one of the medications,
- change one of the medications to another,
- change how you are taking one or both of the medications, or
- leave everything as is.
An interaction between two medications does not always mean that you must stop taking one of them. Speak to your doctor about how any drug interactions are being managed or should be managed.
Medications other than those listed above may interact with this medication. Tell your doctor or prescriber about all prescription, over-the-counter (non-prescription), and herbal medications you are taking. Also tell them about any supplements you take. Since caffeine, alcohol, the nicotine from cigarettes, or street drugs can affect the action of many medications, you should let your prescriber know if you use them.
All material copyright MediResource Inc. 1996 – 2023. Terms and conditions of use. The contents herein are for informational purposes only. Always seek the advice of your physician or other qualified health provider with any questions you may have regarding a medical condition. Source: www.medbroadcast.com/drug/getdrug/Pen-VK
Penicillin – StatPearls – NCBI Bookshelf
Continuing Education Activity
Penicillin is a medication used to manage and treat a wide range of infections. It is in the beta-lactam antibiotic class of drugs. This activity describes penicillin’s indications, action, and contraindications as a valuable agent in treating infection.
In addition, this activity will highlight the mechanism of action, adverse event profile, and other key factors (e.g., off-label uses, dosing, pharmacodynamics, pharmacokinetics, monitoring, relevant interactions) pertinent for interprofessional team members in the treatment of infection.
Objectives:
Identify the mechanism of action of penicillin.
Describe the adverse effects of penicillin.
Describe the administration of penicillin.
Discuss interprofessional team strategies for improving care coordination and communication to advance penicillin administration and improve outcomes.
Access free multiple choice questions on this topic.
Indications
Penicillin is one of the most commonly used antibiotics globally; it has a wide range of clinical indications. Penicillin is effective against many different infections involving gram-positive cocci, gram-positive rods (e.g., Listeria), most anaerobes, and gram-negative cocci (e.
g., Neisseria).[1] Importantly, certain bacterial species have obtained penicillin resistance, including enterococci. Enterococci infections now receive treatment with a combination of penicillin and streptomycin or gentamicin.[2] Certain gram-negative rods are also resistant to penicillin due to penicillin’s poor ability to penetrate the porin channel.[3] However, later generations of broad-spectrum penicillins are effective against gram-negative rods. Second-generation penicillins (ampicillin and amoxicillin) can also penetrate the porin channel, making these drugs effective against Proteus mirabilis, Shigella, H. influenzae, Salmonella, and E. coli. Third-generation penicillin such as carbenicillin is also able to penetrate gram-negative bacterial porin channels. Fourth-generation penicillins such as piperacillin are effective against the same bacterial strains as third-generation penicillins and Klebsiella, enterococci, Pseudomonas aeruginosa, and Bacteroides fragilis.
[4]
Mechanism of Action
Most bacteria have a peptidoglycan cell wall surrounding the bacterial plasma membrane, preventing osmotic lysis and providing structural integrity. The peptidoglycan wall is continually remodeling during replication and growth. Penicillin inhibits the cross-linking of peptidoglycan in the cell wall.[5] The catalyst for this reaction is penicillin-binding proteins, such as the enzyme DD-transpeptidase. Penicillin’s four-membered β-lactam ring can bind to DD-transpeptidase to irreversibly inactive it. The bacteria, therefore, are unable to build their cell walls even while other proteins continue to break down the wall.[6] As the bacteria cell wall continues to weaken, osmotic pressure pushes water into the cell and kills the cell. Peptidoglycan fragments further destroy the cell wall as these fragments can activate autolysins and hydrolases. To enhance its effects, the penicillins can also be combined with a beta-lactamase inhibitor such as clavulanic acid.
Beta-lactamase inhibitors prevent the degradation of the beta-lactam ring in penicillin that can occur when certain species of bacteria express the enzyme beta-lactamase.[7]
Most penicillin derivatives are not metabolized much by the liver. Oral vs. injection will have different bioavailabilities. They are rapidly excreted in the urine as they are water-soluble, and some of the drugs are excreted in bile. Penicillin has a relatively short half-life of about 2 hours.[8]
Administration
Penicillin G administration can be either intravenously or intramuscularly. Penicillin G potassium for injection USP vial is available in 1 million units, 5 million units, and 20 million units per vial. Penicillin G degrades more easily by stomach acid and has less than 30% bioavailability; therefore, it is a parenterally administered drug. Because of the short half-life, penicillin G is usually administered in divided doses 4 to 6 hours apart via the intravenous or intramuscular route.
Penicillin G benzathine administration ensures a continuous low dose of penicillin G over 2 to 4 weeks.
Penicillin V and penicillin VK (potassium salt of penicillin V) is available in orally administered forms as a solution for reconstitution (125 mg/5 mL, 250 mg/5 mL) and tablets (250 mg and 500 mg).[9] Penicillin V has a bioavailability of around 65% after passing stomach acid. Penicillin V is best administered to a fasting patient as it degrades in stomach acid. The normal dose ranges from 125 mg to 500 mg every 6 to 8 hours based on the clinical indication and patient weight.
As with any antibiotic, patients must receive counsel to finish the full medicine course to prevent bacterial resistance. Penicillin demonstrates limited crossing of the blood-brain barrier and can only treat some bacterial meningitis.
Specific Patient Population
Pregnant Women: Penicillin G belongs to FDA pregnancy category B. No severe adverse events are observed with penicillin G.
Elimination of penicillin V is increased during pregnancy, requiring dose adjustment with an increased dose of the standard dosing interval or shorter dosing intervals of the standard dose.[10]
Breastfeeding Women: According to literature, penicillin G and penicillin V can be found in milk at low levels that are unexpected to cause adverse reactions in breastfed infants. It is sometimes reported that penicillin can disrupt the infant’s gastrointestinal flora, causing diarrhea or thrush; however, these side effects have not been adequately evaluated. The penicillin G or penicillin V use is acceptable for nursing mothers.[11][12]
Pediatric Population: The pediatric dose of penicillin is calculated based on their body surface area and weight.
Patients with Renal Impairment: Although renal impairment is not a contraindication for penicillin, doses will have to be adjusted given end-stage renal disease. Depending on the glomerular filtration rate, these patients will receive a full loading dose and then half a loading dose every 8 to 10 hours or 4 to 5 hours.
[13]
Adverse Effects
Penicillin V and G can have adverse effects, including nausea, vomiting, diarrhea, rash, abdominal pain, and urticaria. In addition, Penicillin G can have other adverse reactions, including muscle spasms, fever, chills, muscle pain, headache, tachycardia, flushing, tachypnea, and hypotension.
- Hypersensitivity Reactions: The commonly encountered adverse drug reaction with penicillin is hypersensitivity of immediate onset or delayed onset.
Immediate onset: This kind of reaction occurs within 20 minutes post-administration. It is characterized by urticaria, pruritis, edema, laryngospasm, bronchospasm, hypotension, vascular collapse, and death.
Delayed onset: This reaction occurs within 1 to 2 weeks of treatment. It is rare and is characterized by fever, malaise, urticaria, myalgia, arthralgia, abdominal pain, and skin rashes.[14]
Gastrointestinal System: GI symptoms were the most common and were reported in over 1% of patients, including nausea, vomiting, stomatitis, which are commonly observed with oral administration.
Pseudomembranous colitis is also observed during or after the treatment.
Hematologic Reactions: If the dose is exceeded 10 million units/day and if a patient has received a higher dose previously, then those patients can precipitate Coombs positive hemolytic anemia and neutropenia, which is resolved when therapy is stopped.
Metabolic Reactions: The salt form of penicillin G may cause electrolyte imbalances, i.e., hyperkalemia when given IV in a large dose.
Nervous System: Neurological manifestations include hyperreflexia, myoclonic twitches, seizures, and coma after IV doses and are more likely in patients with impaired renal function.
Urogenital System: Urological manifestations with large IV doses include renal tubular damage. The penicillins can also cause acute interstitial nephritis, a disease characterized by inflammation of the tubules and interstitium of the kidneys.
[15] Acute interstitial nephritis can also present with hematuria, fever, and rash. The recommendation is to withdraw the drug as the disease could lead to renal failure in this situation.
Other: Jarisch- Herxheimer reaction is precipitated when penicillin is administered in patients with syphilis.
Drug-Drug Interactions
Concurrent sulfonamides, erythromycin, chloramphenicol should be avoided due to antagonistic effects.
Tubular secretion of penicillin G can be blocked by probenecid- higher and longer plasma concentrations are achieved. Probenecid also decreases the volume of distribution of penicillin.
Drugs like aspirin, phenylbutazone, sulfonamides, indomethacin, thiazide, furosemide, and ethacrynic acid increase the half-life of penicillin by competing with tubular secretion.
Contraindications
Contraindications of penicillin include a previous history of severe allergic reactions or penicillin and its derivatives.
Penicillin is also contraindicated in patients who have had Stevens-Johnson syndrome after administering penicillin or a penicillin derivative. The penicillins are safe to use during pregnancy and nursing, as the drug appears at a low concentration in breastmilk. Penicillin has an antagonistic effect with tetracycline and reportedly can lead to 2.6 times greater risk for mortality when treating pneumococcal meningitis than using penicillin alone.[16] Penicillin requires bacterial cell wall synthesis to be active to be effective.
Nearly all antibacterial agents have been linked to Clostridium difficile associated diarrhea (CDAD), including penicillin, with severity ranging from mild diarrhea to fatal colitis. The use of antibacterial agents alters the normal flora of the colon, causing the overgrowth of C. difficile. This strain produces toxins A and B that contribute to the development of CDAD. During infections caused by hyper toxin-producing strains of C. difficile, the rate of morbidity and mortality can be increased since these infections are often resistant to antimicrobial treatments and may require colectomy.
When C. difficile-associated diarrhea (CDAD) is suspected or confirmed, ongoing antibiotic treatment is recommended to stop. Depending on clinical need, protein supplementation, fluid and electrolyte management, antibiotic treatment, and surgical evaluation should be implemented.[17]
Monitoring
Generally, the monitoring of patients on penicillin is not required. However, one study recommended therapeutic drug monitoring during endocarditis treatment caused by enterococci to better determine penicillin exposure and dosing. This vigilance will decrease the chance of antibiotic resistance while improving therapeutic impact.[18] With long-term administration of penicillin, it may be necessary to monitor hematologic, renal, and hepatic function.
Toxicity
Penicillin has a small risk of toxicity. Compared to other biologically active substances, clinicians can administer these drugs at relatively high doses without harming patients. Estimates are that it would take 5 g/kg body weight intravenously to cause convulsions in a patient.
However, penicillin can cause local toxicity due to high dose injections at sensitive sites such as the anterior chamber of the eye or the subarachnoid space. There are reports that pure preparations of penicillin cause no harm to the lungs and veins. Other reports indicate that topical penicillin can prevent coagulation in dental cavities.[19]
Enhancing Healthcare Team Outcomes
Before prescribing penicillin to a patient, the clinician and healthcare team should confirm that the underlying infection is likely the result of a bacteria that is sensitive to penicillin. The clinician, pharmacist, and/or nurse should also tell the patient of any side effects of the drug that should prompt a return visit, such as prolonged diarrhea or serious rash. In an outpatient setting, communication between the clinician and the pharmacist will allow the drug to be dispensed appropriately to the patient. The pharmacist should consult the patient on how best to administer the penicillin and remind them that they should complete the entire course of the antibiotic.
This interprofessional approach will optimize therapeutic results while minimizing adverse effects. [Level 5]
Should a patient have difficulty obtaining drugs for either financial or logistical reasons, a social worker may help assure that the patient receives their medications. In an inpatient setting, communication between the clinician and the nurse will allow the patient to receive the drug. The healthcare team can work together to confirm that the patient does not have any contraindications to penicillin use. If any immediate serious adverse effects occur after administering penicillin, such as anaphylaxis, the healthcare team should receive notification and treat the acute condition immediately. A board-certified infectious disease pharmacist can also consult on the case to confirm if penicillin is the best choice given the patient’s diagnosis and any other medications that the patient might be taking. Furthermore, a flattened hierarchy approach should be in place to ensure that reporting mistakes to a superior can take place without resistance.
Utilization of the entire healthcare team is critical to ensure that the patient is comfortable and has the best medical outcome with the lowest chance of complications.
Review Questions
Access free multiple choice questions on this topic.
Comment on this article.
References
- 1.
Friedland IR, McCracken GH. Management of infections caused by antibiotic-resistant Streptococcus pneumoniae. N Engl J Med. 1994 Aug 11;331(6):377-82. [PubMed: 8028618]
- 2.
Herman DJ, Gerding DN. Antimicrobial resistance among enterococci. Antimicrob Agents Chemother. 1991 Jan;35(1):1-4. [PMC free article: PMC244931] [PubMed: 1901693]
- 3.
Spratt BG, Cromie KD. Penicillin-binding proteins of gram-negative bacteria. Rev Infect Dis. 1988 Jul-Aug;10(4):699-711. [PubMed: 3055170]
- 4.
Perry CM, Markham A. Piperacillin/tazobactam: an updated review of its use in the treatment of bacterial infections.
Drugs. 1999 May;57(5):805-43. [PubMed: 10353303]- 5.
Fisher JF, Mobashery S. Constructing and deconstructing the bacterial cell wall. Protein Sci. 2020 Mar;29(3):629-646. [PMC free article: PMC7021008] [PubMed: 31747090]
- 6.
Gordon E, Mouz N, Duée E, Dideberg O. The crystal structure of the penicillin-binding protein 2x from Streptococcus pneumoniae and its acyl-enzyme form: implication in drug resistance. J Mol Biol. 2000 Jun 02;299(2):477-85. [PubMed: 10860753]
- 7.
Espinosa-Gongora C, Jessen LR, Kieler IN, Damborg P, Bjørnvad CR, Gudeta DD, Pires Dos Santos T, Sablier-Gallis F, Sayah-Jeanne S, Corbel T, Nevière A, Hugon P, Saint-Lu N, de Gunzburg J, Guardabassi L. Impact of oral amoxicillin and amoxicillin/clavulanic acid treatment on bacterial diversity and β-lactam resistance in the canine faecal microbiota. J Antimicrob Chemother. 2020 Feb 01;75(2):351-361. [PubMed: 31778166]
- 8.
Barker CI, Germovsek E, Sharland M.
What do I need to know about penicillin antibiotics? Arch Dis Child Educ Pract Ed. 2017 Feb;102(1):44-50. [PubMed: 27412043]- 9.
LiverTox: Clinical and Research Information on Drug-Induced Liver Injury [Internet]. National Institute of Diabetes and Digestive and Kidney Diseases; Bethesda (MD): Oct 20, 2020. Penicillins (1st Generation) [PubMed: 31644108]
- 10.
Heikkilä AM, Erkkola RU. The need for adjustment of dosage regimen of penicillin V during pregnancy. Obstet Gynecol. 1993 Jun;81(6):919-21. [PubMed: 8497356]
- 11.
Drugs and Lactation Database (LactMed®) [Internet]. National Institute of Child Health and Human Development; Bethesda (MD): Feb 15, 2021. Penicillin V. [PubMed: 30000121]
- 12.
Drugs and Lactation Database (LactMed®) [Internet]. National Institute of Child Health and Human Development; Bethesda (MD): Feb 15, 2021. Penicillin G. [PubMed: 30000119]
- 13.
Smyth B, Jones C, Saunders J.
Prescribing for patients on dialysis. Aust Prescr. 2016 Feb;39(1):21-4. [PMC free article: PMC4816865] [PubMed: 27041803]- 14.
Bhattacharya S. The facts about penicillin allergy: a review. J Adv Pharm Technol Res. 2010 Jan;1(1):11-7. [PMC free article: PMC3255391] [PubMed: 22247826]
- 15.
Finnigan NA, Bashir K. StatPearls [Internet]. StatPearls Publishing; Treasure Island (FL): Jan 22, 2023. Allergic Interstitial Nephritis. [PubMed: 29493948]
- 16.
Levison ME, Levison JH. Pharmacokinetics and pharmacodynamics of antibacterial agents. Infect Dis Clin North Am. 2009 Dec;23(4):791-815, vii. [PMC free article: PMC3675903] [PubMed: 19909885]
- 17.
Smits WK, Lyras D, Lacy DB, Wilcox MH, Kuijper EJ. Clostridium difficile infection. Nat Rev Dis Primers. 2016 Apr 07;2:16020. [PMC free article: PMC5453186] [PubMed: 27158839]
- 18.
Öbrink-Hansen K, Wiggers H, Bibby BM, Hardlei TF, Jensen K, Kragh Thomsen M, Brock B, Petersen E.
Penicillin G Treatment in Infective Endocarditis Patients – Does Standard Dosing Result in Therapeutic Plasma Concentrations? Basic Clin Pharmacol Toxicol. 2017 Feb;120(2):179-186. [PubMed: 27565458]- 19.
STEWART GT. TOXICITY OF THE PENICILLINS. Postgrad Med J. 1964 Dec;40(Suppl):SUPPL:160-9. [PMC free article: PMC2483108] [PubMed: 14246836]
Disclosure: Derek Yip declares no relevant financial relationships with ineligible companies.
Disclosure: Valerie Gerriets declares no relevant financial relationships with ineligible companies.
the first antibiotic that saves the lives of thousands of people
Contents
- 1 Penicillin – the first antibiotic in the history of medicine
- 1.1.2 Health effects of penicillin
- 1.1.3 Conclusion
- 1.2 Discovery of the first antibiotic
- 1.3 Found remedy for the treatment of infections during the Second World War
- 1.
4 History of the discovery of penicillin- 1.4.1 The discovery of penicillin
- 1.4.2 Historical evidence
- 1.5 The effect of penicillin on infectious diseases
- 1.6 Penicillin, the first antibiotic that saves thousands of lives
- 90 005 1.6.1 What is penicillin?
- 1.6.2 How is penicillin used in modern medicine?
- 1.10.1 What are the side effects of penicillin?
- 1.10.2 How to minimize side effects when taking penicillin?
- 1.14.0.1 What are the main properties of penicillin?
- 1.
14.0.2 How is penicillin used in medicine? - 1.14.0.3 How was penicillin discovered?
- 1.14.0.4 How did penicillin help during World War II?
- 1.14.0.5 What side effects can penicillin cause?
- 1.14.0.6 Can penicillin be used to prevent infections?
Penicillin is the first antibiotic in the history of medicine, which became a real breakthrough in the treatment of infectious diseases. Find out how penicillin was discovered, how it works and what diseases it can cure.
The progress of medicine over the past centuries is amazing: we are identifying and treating diseases that seemed hopeless before. Thanks to the invention of the first antibiotic – penicillin – it became easier and more effective to protect against germs and bacteria. Today we can talk about a holistic picture of the successes and achievements of the humanities and medicine thanks to this incredible drug.
The outstanding knowledge of scientists and the courage of people who led the fight against ailments gave impetus to the creation of a proactive medical world that can prevent and treat many diseases.
However, during the centuries of struggle with rapidly spreading bacteria, Eastern Europe in the form of Alexander Fleming, Ernst Borget and Howard Flory contributed to the revolution and deep development of medical practice.
On the way to the creation of the first antibiotic, scientists had to go through many difficulties, but the risk paid off. Penicillin changed the future of medicine, making it work for the person, not against him. The unique discoveries greatly influenced modern medical practice and provided opportunities for the further development of biomedicine.
Penicillin: History and Health Effects
The History of the Discovery of Penicillin
Penicillin was the first mass-produced antibiotic that was successfully used to treat infections. Its discovery happened quite by accident at 1928 thanks to the work of the English scientist Alexander Fleming. Fleming noticed that one of the plates on which he was growing bacteria had developed a mold that inhibited the growth of bacteria.
Moreover, it turned out to destroy some types of bacteria. This important point became the basis for further research in the field of obtaining penicillin.
Fleming’s discovery acquired practical significance a few years later, when he was lucky, together with other scientists, to obtain truly pure penicillin and show its high efficiency in the treatment of infectious diseases.
Health effects of penicillin
The discovery of penicillin caused a revolution in medicine and saved thousands of lives. If before that the treatment of infections was rather complicated and often ineffective, now it was possible to get rid of bacterial infections with the help of a simple and safe medicine.
Today, infections that used to be incurable diseases can be easily treated with antibiotics, and in some cases even in a matter of days. Therefore, penicillin and other antibiotics play a huge role in maintaining human health and preventing dangerous epidemics.
Conclusion
The discovery of penicillin is not only recognized as the most important medical discovery of the 20th century, but is also considered one of the most important scientific discoveries in human history.
The main significance of the discovery lies in the fact that thanks to penicillin, the possibility of combating bacterial diseases was proven and countless lives were saved.
Discovery of the first antibiotic
In 1928, Alexander Fleming accidentally discovered penicillin, the first antibiotic that saved many lives on Earth.
The use of penicillin has revolutionized medicine and is now being used to fight many infections such as pneumonia, sepsis, urinary tract infections and others.
- Penicillin helps save many lives by fighting dangerous infections essential to human survival;
- The use of penicillin helped discover new treatments and drugs to fight other infections;
- Penicillin continues to be one of the most effective antibiotics to this day.
Penicillin is the stepping stone on which doctors and scientists have built a range of new drugs to help fight various diseases and heal people.
Found remedy for the treatment of infections during the Second World War
During the Second World War, many lives were destroyed not only from enemy attacks, but also from infections that could not be treated.
However, a way has been found to deal with this problem.
In 1928, the British microbiologist Alexander Fleming discovered that due to mutated bacteria, a culture of Staphylococcus did not grow around a mold he was growing on a nutrient medium. This discovery was the starting point in the development of the first antibiotic.
Penicillin was discovered in 1928 as a treatment for infections and was successfully used to treat war wounds during World War II. Penicillin helped save the lives of thousands of wounded who had infections and other complications after surgery.
The discovery of the first antibiotic significantly changed medicine and contributed to the development of new methods of treatment in the fight against infections and diseases. Today, antibiotics play a key role in the treatment of infections and save hundreds of thousands of lives a year around the world.
History of the discovery of penicillin
Discovery of penicillin
Penicillin is the first antibiotic that saved the lives of thousands of people.
His discovery was one of the greatest scientific achievements of the 20th century. It was opened in 1928 by Alexander Fleming, who worked at the University of London. He noticed that molds appeared on the petri dishes with bacteria on which he worked. He also noticed that where there were molds, bacteria did not grow. This led to the discovery of penicillin, the first antibiotic.
Historical evidence
Historical evidence shows that penicillin was used during World War II to treat wounded soldiers. In 1945, Alexander Fleming, Howard Florey, and Ernst Chain were recognized as Nobel Prize winners in Physiology or Medicine for their work on penicillin, the first antibiotic. Since 1940, penicillin has been widely used in medicine, and this has led to a revolution in the treatment of infectious diseases. Today’s antibiotics are the heirs of penicillin, and many lives have been saved thanks to this discovery.
The effect of penicillin on infectious diseases
Penicillin is the first antibiotic discovered by man.
It is a powerful drug that can fight most types of infectious diseases.
When the cell wall of a microorganism is destroyed, it loses its vital capacity and dies. Thus, penicillin protects the body from infectious diseases, destroying the causative agent of the disease.
It should be noted that not all types of bacteria are sensitive to penicillin. Therefore, antibiotic susceptibility testing is essential for effective treatment of infections.
- Penicillin benefits:
- Broad spectrum;
- Few side effects;
- High efficiency in the treatment of infectious diseases;
- Lack of addiction to the drug and the development of microbial resistance.
- Penicillin benefits:
Penicillin is a drug that has long established itself as a reliable and effective drug for the treatment of infections. However, it should only be used if indicated and under medical supervision.
Penicillin – the first antibiotic that saves the lives of thousands of people
What is penicillin?
Penicillin is the first antibiotic discovered by Alexander Fleming in 1928.
The drug is produced from the biomass of the producer fungus. It is a broad-spectrum beta-lactam antibiotic, which is the main dosage form of penicillin.
How is penicillin used in modern medicine?
Unfortunately, there are microorganisms that can develop resistance against penicillin. However, it is still widely used in the treatment of many infectious diseases, such as tonsillitis, scarlet fever, pneumonia, sepsis, gonorrhea, etc. There are many new forms of it, such as amoxicillin, augmentin, etc.
The beauty of penicillin is that it seems to be absolutely harmless; does not cause any side effects and can be increased in size and infinitely improved until it reaches its limit like Mach.
– Ernest Hemingway, 1940
Transforming medicine with penicillin
Penicillin is an antibiotic that has revolutionized medicine and has led to huge changes in the treatment of various infectious diseases.
Previously, bacterial infections were one of the main threats to human health, since there was no way to deal with microorganisms.
However, after the discovery of penicillin, it became possible to effectively fight bacteria, which led to a significant reduction in mortality and morbidity.
The use of penicillin made it possible for medicine to move further, to begin the study of other microorganisms and the development of other antibiotics.
Today, antibiotics are widely used throughout the world, they have become an effective medicine that saves lives and leads to the recovery of sick people. In general, medical science as a whole has made a significant contribution to the fight against infectious diseases over the past few decades due to the tremendous progress and development in the field of treating bacteria.
How does penicillin help fight infections?
Penicillin is an antibiotic that was discovered in 1928. It is the first antibiotic to effectively fight bacterial infections and save thousands of lives.
Penicillin works by killing bacteria that can lead to infections.
It does this by blocking the production of the bacterial cell wall, which causes the bacteria to die.
Penicillin can effectively fight many infections such as pneumonia, syphilis, and urinary tract and respiratory tract infections.
However, do not confuse penicillin with a universal medicine that will help get rid of any infection. Each type of bacteria is resistant to different types of antibiotics, including penicillin.
Examples of infections that can be treated with penicillin Respiratory tract infections Urinary tract infections Skin and soft tissue infections
| Bronchitis, pneumonia |
| Cystitis, pyelonephritis |
| Herpes zoster, boil, lymphangitis |
Penicillin is an important medicine that can stop many infections. The use of penicillin must necessarily be accompanied by a diagnosis and selection of appropriate doses in order to achieve maximum effectiveness and overcome a bacterial infection.
Technologies for the production of penicillin
Production of penicillin on an industrial scale requires special technologies and conditions. First of all, initially you need to get a strain of cultures of microorganisms, from which penicillin can be isolated. This strain is grown in special bacteriological gurneys for several days.
Penicillin production step Description
| Culture of microorganisms | Process for obtaining a strain that is used to isolate penicillin |
| Enzymatic process | Process for digesting proteins and isolating penicillin |
| Purification and concentration | Removal of excess elements and increasing the content of penicillin in solution |
The penicillin is then sterilized and filled into glass vials or ampoules. Such penicillin can be stored for up to 3 years and used to treat various infections.
The use of penicillin changed medicine forever, it became the first drug capable of neutralizing many infections that were previously considered incurable.
There are other antibiotics now available, but penicillin is still the most important treatment for bacterial infections.
Penicillin and its side effects
What are the side effects of penicillin?
Various side effects may occur when taking penicillin, including: diarrhea, nausea and vomiting
Important! If you experience any side effects after taking penicillin, you should contact your doctor immediately.
How to minimize side effects when taking penicillin?
To minimize side effects when taking penicillin, it is recommended:
- take the medicine exactly as prescribed by the doctor and in the indicated doses
- avoid drinking alcohol
- read the label before taking the medicine and make sure there are no contraindications
- tell your doctor about any other medicines you are taking
- monitor your health and respond to any strange symptoms
9 0171
Observing these recommendations, you can minimize the risk of side effects when taking penicillin and get the maximum benefit from this drug.
Is there a better way to fight infections than penicillin?
Penicillin was discovered in 1928 and was the first antibiotic to save thousands of lives around the world. He successfully fights various infectious diseases such as pneumonia, sepsis and scarlet fever.
Despite the success of penicillin, new antibiotics have since been developed that may be more effective in fighting infections. For example, azithromycin and ceftriaxone is often used to treat any bacterial infection, including pneumonia and sepsis, that has previously been treated with penicillin.
However, penicillin is still a widely used drug due to its safety and availability. In addition, it is used to treat certain types of infections that cannot be treated by other means.
Conclusion: Penicillin was a revolutionary discovery in medicine, but new antibiotics appear regularly and may be more effective in fighting infectious diseases.
However, penicillin still remains an important tool in the treatment of infections due to its availability and safety.
Penicillin mysteries and the future
Although penicillin has been discovered and used since the 1940s, there are many mysteries that still remain unresolved.
Question 1: Why did some bacteria become resistant to penicillin? It seems that every year more and more species of bacteria develop immunity to this antibiotic. Are bacteria getting smarter than antibiotics?
Question 2: Is it possible to create more effective antibiotics based on penicillin? Scientists are still researching the properties and possibilities of this antibiotic in order to possibly create a new drug with fewer side effects and a wider spectrum of action.
Question 3: How can the misuse of penicillin be prevented? There is a danger that the antibiotic will be used incorrectly, which can lead to the creation of bacteria that become even more resistant to the drugs.
It is necessary to develop strict rules for the use of penicillin and educate people on how to use it correctly.
Question 4: What will be the consequences if we cannot fight bacteria that have already become resistant to penicillin? Scientists are ringing big bells, warning the public of a possible epidemic if we can’t find new antimicrobials.
The future of penicillin depends on our ability to handle it and develop new antibiotics. New discoveries and research could successfully counter resistance threats and keep penicillin as an effective and safe treatment for bacterial infections.
Related videos:
Q&A:
What are the main properties of penicillin?
Penicillin has a bactericidal effect, that is, it destroys bacteria, and not only slows down their reproduction.
It also has a wide spectrum of activity, covering many types of bacteria, including those that cause life-threatening diseases. In addition, penicillin is relatively safe and does not cause serious side effects.
How is penicillin used in medicine?
Penicillin is used to treat many infections such as pneumonia, sepsis, meningitis, acute respiratory infections, syphilis, gonorrhea, staph infections, and others. It is used both in the form of tablets or capsules, and in the form of injections. However, it is worth noting that penicillins may not be suitable for treating certain infections, as the bacteria may be resistant to them.
How was penicillin discovered?
Penicillin was discovered at 1928 by the British scientist Alexander Fleming. He found that the mold Penicillium notatum, which got on a petri jar with bacteria, killed them. Thus, the first antibiotic was discovered.
How did penicillin help during World War II?
During World War II, penicillin was used to treat infectious diseases caused by various types of bacteria that spread among the wounded on the battlefield.
Penicillin has saved thousands of lives.
What side effects can penicillin cause?
Despite the relative safety, the use of penicillin may cause side effects such as allergic reactions, diarrhea, nausea, vomiting, abdominal pain and others. In rare cases, anaphylactic shock caused by an allergic reaction to penicillin may occur.
Can penicillin be used to prevent infections?
Penicillin is not recommended for use as an infection prophylaxis as it may lead to the development of bacterial resistance. The best way to prevent infections is to follow the rules of hygiene, vaccinations and other preventive measures.
The history of the discovery of penicillin. Dossier – TASS
February 11, 2016, 19:22
TASS-DOSSIER / Yulia Kovaleva /. 75 years ago, on February 12, 1941, in London, British scientists Howard Florey and Ernst Cheyne first used penicillin to treat humans. The editors of TASS-DOSIER have prepared material on the history of the discovery of this drug.
Penicillin is an antibiotic with broad antimicrobial activity. It is the first effective medicine against many serious diseases, in particular, syphilis and gangrene, as well as infections caused by staphylococci and streptococci. It is obtained from certain types of fungus of the genus Penicillium (Latin penicillus – “brush”; under a microscope, spore-bearing mold cells look like a brush).
History of discovery
Mentions about the use of mold for medicinal purposes are found in the writings of the Persian scientist Avicenna (II century) and the Swiss physician and philosopher Paracelsus (XIV century). The Bolivian ethnobotanist Enrique Oblitas Poblete in 1963 described the use of mold by Indian healers in the Inca era (XV-XVI centuries).
In 1896, the Italian physician Bartolomeo Gosio, studying the causes of mold damage to rice, developed an antibiotic formula similar to penicillin. Due to the fact that he could not offer a practical application of a new drug, his discovery was forgotten.
At 189In 7, French military doctor Ernest Duchen noticed that Arab grooms collected mold from damp saddles and treated the wounds of horses with it. Duchen carefully examined the mold, tested it on guinea pigs and found its destructive effect on the typhoid bacillus. Ernest Duchen presented the results of his research at the Pasteur Institute in Paris, but they were also not recognized. In 1913, American scientists Carl Alsberg and Otis Fisher Black succeeded in obtaining an acid with antimicrobial properties from mold, but their research was interrupted by the outbreak of the First World War.
Read also
Aerosol from the Ministry of Health as an alternative to antibiotics can be used in schools
In 1928, the British scientist Alexander Fleming conducted an ordinary experiment in the course of studying the resistance of the human body to bacterial infections. He found that some colonies of staphylococcal cultures he left in laboratory dishes were infected with a strain of the mold Penicillium Notatum.
Around the mold spots, Fleming noticed an area that was free of bacteria. This allowed him to conclude that the mold produces a bacteria-killing substance that the scientist called “penicillin”.
Fleming underestimated his discovery, believing it would be very difficult to obtain a cure. His work was continued by Oxford scientists Howard Florey and Ernst Chain. In 1940, they isolated the drug in its pure form and studied its therapeutic properties. On February 12, 1941, an injection of penicillin was given to a human for the first time. Flory and Cheyne’s patient was a London policeman who was dying of blood poisoning. After several injections, he felt better, but the supply of medicine quickly ran out, and the patient died. At 191943 Howard Flory transferred the technology for obtaining a new drug to American scientists, mass production of an antibiotic was established in the USA. In 1945, Alexander Fleming, Howard Florey and Ernst Chain were awarded the Nobel Prize in Physiology or Medicine.
Research by Russian and Soviet scientists
In the 1870s. mold was studied by doctors Alexei Polotebnov and Vyacheslav Manassein, who found that it blocks the growth of other microorganisms. Polotebnov recommended using these features of mold in medicine, in particular, for the treatment of skin diseases. But the idea didn’t catch on.
In the USSR, microbiologists Zinaida Ermolyeva and Tamara Balezina received the first samples of penicillin. In 1942, they discovered a penicillin-producing strain of Penicillium Crustosum. During the trials, the drug showed much greater activity than its English and American counterparts. However, the resulting antibiotic lost its properties during storage and caused an increase in temperature in patients.
In 1945, the Soviet Union began testing penicillin, developed according to the Western model. The technology of its production was mastered by the Research Institute of Epidemiology and Hygiene of the Red Army under the leadership of Nikolai Kopylov.

Pseudomembranous colitis is also observed during or after the treatment.
[15] Acute interstitial nephritis can also present with hematuria, fever, and rash. The recommendation is to withdraw the drug as the disease could lead to renal failure in this situation.
Drugs. 1999 May;57(5):805-43. [PubMed: 10353303]
What do I need to know about penicillin antibiotics? Arch Dis Child Educ Pract Ed. 2017 Feb;102(1):44-50. [PubMed: 27412043]
Prescribing for patients on dialysis. Aust Prescr. 2016 Feb;39(1):21-4. [PMC free article: PMC4816865] [PubMed: 27041803]
Penicillin G Treatment in Infective Endocarditis Patients – Does Standard Dosing Result in Therapeutic Plasma Concentrations? Basic Clin Pharmacol Toxicol. 2017 Feb;120(2):179-186. [PubMed: 27565458]
4 History of the discovery of penicillin
14.0.2 How is penicillin used in medicine?